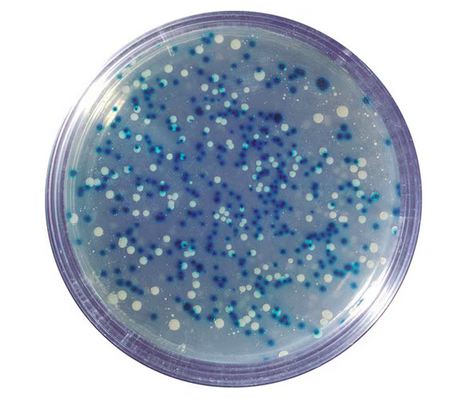

In the world of molecular biology, we’re lucky to have a whole roster of heroes. One of them goes by the name X-gal. A bit of a chameleon, this hero has a unique superpower: the ability to reveal secrets hidden in plain sight. She may not have a cape or flashy armor, but with a single color change, she can transform a bland petri dish into a vivid map of what’s happening inside cells. And thanks to her, scientists can use just their regular (non-superpowered) eyesight to spot colonies they’ve successfully edited or see enzyme activity in tissues and cells. Read on to discover more about X-gal—and see how you can join forces with her in your next lab or classroom experiment!
Origin Story
Every superhero has an origin story, and X-gal is no exception! She was first created in 1964 by scientist Jerome Horwitz and his team, who cleverly linked galactose (a simple sugar) to a molecule called indole. The result? 5-bromo-4-chloro-3-indolyl-β-D-galactopyranoside—though her friends just call her X-gal. Why the “X”? That’s her little mystery. But while her name might leave you guessing, her power is anything but ambiguous.
Superpower
X-gal’s superpower lies in her ability to transform from invisible to vivid blue when she detects a specific enzyme: β-galactosidase (or “beta-gal” if you’re on friendly terms). Here’s how it works: X-gal is cleverly designed to resemble lactose (a type of sugar), so β-galactosidase, an enzyme that naturally breaks down lactose, “unlocks” her. When it does, X-gal splits into two molecules, one of which reacts with oxygen in the air to produce a striking, unmistakable blue color!
This reaction isn’t just for show—it’s incredibly useful in labs. By adding X-gal to an experiment, scientists can quickly spot which cells or colonies are expressing β-galactosidase just by looking for that signature blue color.
Allies
Even superheroes need a sidekick, and X-gal’s inside gal is the enzyme β-galactosidase—also known as “β-gal” for short. Think of β-gal as X-gal’s partner in crime-fighting (or, in this case, color-changing). β-gal’s talent? She cuts molecules right at the perfect spot, typically lactose, especially when oxygen is scarce. But when β-gal meets X-gal, they paint the town blue: β-gal cleaves X-gal to release her signature color. Together, they’re an unstoppable duo, transforming clear petri dishes into vibrant maps of enzyme activity.
X-gal’s team often includes another key player: IPTG (isopropyl β-D-1-thiogalactopyranoside). IPTG acts as a “molecular switch,” turning on the lac operon, which triggers the production of β-gal. By adding IPTG to an experiment, scientists can make sure β-gal is primed to activate X-gal’s color change whenever needed. This combination of X-gal and IPTG increases the test’s sensitivity and the experimenter’s control leading to a powerful setup that’s easy to interpret and perfect for lab screenings.
Super-powered Variants
Like many heroes, X-gal has several powerful “variants”—molecular cousins with slight differences that give them unique abilities. Each variant works like X-gal, but instead of turning blue, they reveal themselves in a spectrum of colors. They include: 5-Bromo-3-indolyl β-D-galactopyranoside (dark blue), 6-Chloro-3-indolyl-β-D-galactopyranoside (pink), 5-Iodo-3-indolyl-β-D-galactopyranoside (purple), 5-Bromo-6-chloro-3-indolyl-β-D-glucopyranoside (purple), N-Methylindolyl-β-D-galactopyranoside (green), and N-Methylindolyl-β-D-galactopyranoside (fluorescent).
Her Most Famous Episode: The Blue-White Screening
In the sprawling landscape of Petri City, scientists are on a mission: to find cells that carry a precious piece of DNA, one that could hold answers to their research questions and goals. But locating the cells that successfully took up this DNA isn’t easy—they all look identical to the naked eye. It’s a challenge tailor-made for a superhero. Enter X-gal, the fearless color-changer with the power to expose what lies hidden.
Armed with her trusty sidekicks, β-gal and IPTG, X-gal takes on her mission. Together, they transform the Petri City plates, bringing out the colors needed to reveal the truth. Here’s how it works: cells that have accepted the target DNA have a disrupted LacZ gene (due to the inserted gene of interest) and cannot produce β-gal. This means that even in the presence of X-gal and IPTG, they remain white. On the other hand, cells that have not accepted the target DNA have an intact LacZ gene which, when induced by IPTG, leads to the expression of β-gal. This, in turn, leads to the cleavage of X-gal and a color change to blue. With the plate now color-coded into white and blue, it’s easy for scientists to spot and select the transformed cells for the next stage of the experiment. (For more biological details on blue-white screening, check out this link.)
Thanks to the dynamic, color-changing teamwork of X-gal, β-gal, and IPTG, scientists can swiftly and cost-effectively pinpoint the cells that carry their target DNA. Mission accomplished!
Final Words
X-gal’s powers extend well beyond bacterial screening. In genetics, cell biology, and medical research, she’s a trusted ally. With just a flash of blue, X-gal reveals hidden truths, making complex cells easier to interpret.
Ready to add X-gal to your experimental lineup? Explore our classroom experiments 221 or 300 and experience the excitement and power of this super reagent firsthand!